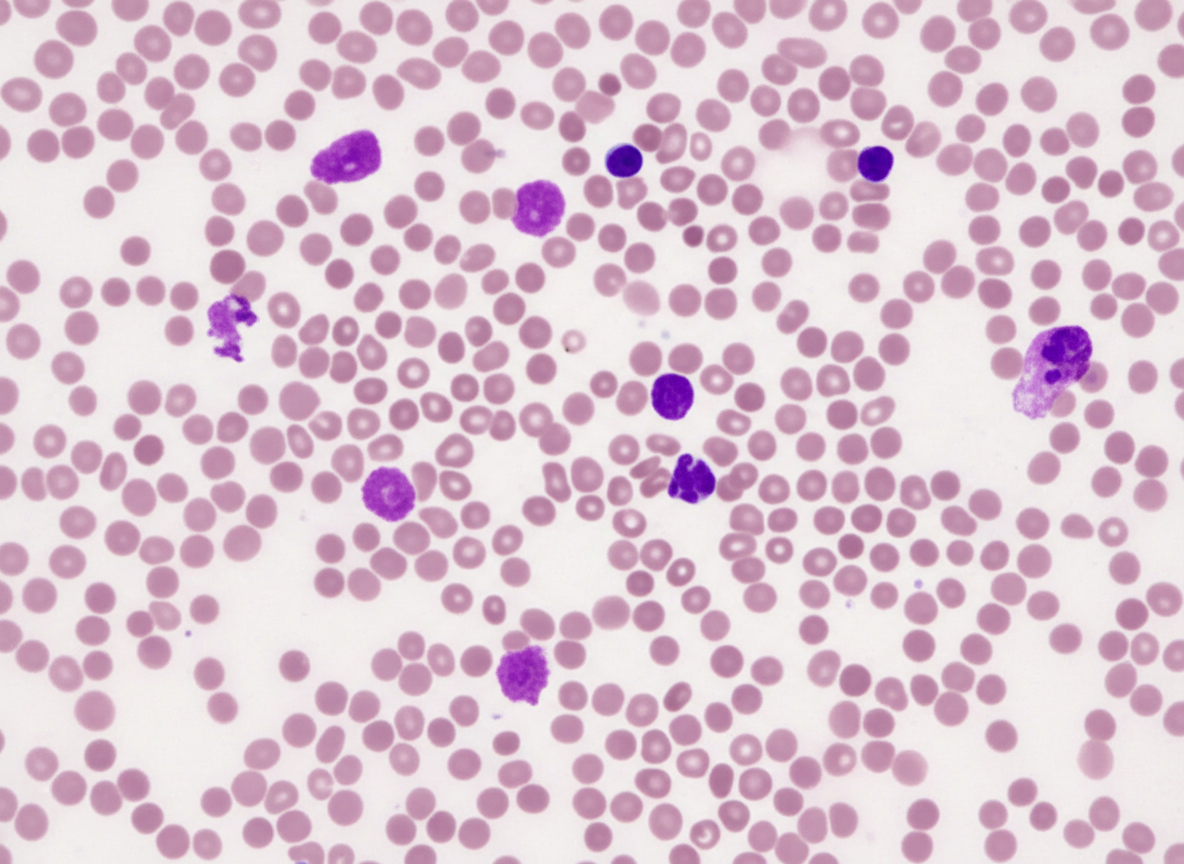
Image for question 1064

A 69-year-old man presents for a general follow up appointment. He states that he is doing well and wants to be sure he is healthy. The patient’s past medical history is significant for type II diabetes mellitus, peripheral vascular disease, and hypertension. His current medications include metformin, glyburide, lisinopril, metoprolol and hydrochlorothiazide. His blood pressure is 130/90 mmHg and pulse is 80/min. A fasting lipid panel was performed last week demonstrating an LDL of 85 mg/dL and triglycerides of 160 mg/dL. The patient states that he has not experienced any symptoms since his last visit. The patient’s blood glucose at this visit is 100 mg/dL. Which of the following is recommended in this patient?
A 16-year-old boy with a history of severe, persistent asthma presents to the emergency department with severe shortness of breath and cough. He states that he was outside playing basketball with his friends, forgot to take his inhaler, and began to have severe difficulty breathing. On exam, he is in clear respiratory distress with decreased air movement throughout all lung fields. He is immediately treated with beta-agonists which markedly improve his symptoms. Prior to treatment, which of the following was most likely observed in this patient?
A 68-year-old woman is brought to the emergency department by ambulance after she was found down by her daughter. She lives alone in her apartment so it is unclear when she began to develop symptoms. Her medical history is significant for cardiac arrhythmias, diabetes, pericarditis, and a stroke 2 years ago. On presentation her temperature is 98.1°F (36.7°C), blood pressure is 88/51 mmHg, pulse is 137/min, and respirations are 18/min. On physical exam her skin is cold and clammy. If special tests were obtained, they would reveal dramatically decreased pulmonary capillary wedge pressure, increased systemic vascular resistance, and mildly decreased cardiac output. Which of the following treatments would most directly target the cause of this patient's low blood pressure?
A 72-year-old man comes to the physician because of fatigue and a 5-kg (11-lb) weight loss over the past 6 months despite a good appetite. He takes no medications. He does not smoke or use illicit drugs. Physical examination shows hepatosplenomegaly and diffuse, nontender lymphadenopathy. Laboratory studies show a hemoglobin concentration of 11 g/dL and a leukocyte count of 16,000/mm3. A direct antiglobulin (Coombs) test is positive. A photomicrograph of a peripheral blood smear is shown. Which of the following is the most likely diagnosis?
A 72-year-old woman with a medical history significant for chronic kidney disease stage 4, hypertension, and type 2 diabetes mellitus, presents to the office for a scheduled visit. During her last visit, the physician started discussing with her the possibility of starting her on dialysis for her chronic kidney disease. The patient has no complaints about her health and enjoys spending time with her family. At presentation, she is afebrile; the blood pressure is 139/89 mm Hg and the heart rate is 80/min. On physical examination, her pulses are bounding, the complexion is pale, she has a grade ⅙ holosystolic murmur, breath sounds remain clear, and 2+ pedal edema to the knee. The measurement of which of the following laboratory values is most appropriate to screen for renal osteodystrophy in this patient?
A 44-year-old woman presents to her physician’s office for weakness. She reports having some difficulty placing books on a high shelf and getting up from a seated position. She denies muscle pain or any new rashes. She has noticed a tremor that is worse with action and has been having trouble falling asleep and staying asleep. She has lost approximately 10 pounds unintentionally over the course of 2 months. Medical history is significant for type I diabetes mellitus managed with an insulin pump. Family history is notable for systemic lupus erythematosus in her mother and panic disorder in the father. Her temperature is 98.6°F (37 °C), blood pressure is 140/85 mmHg, pulse is 102/min, and respirations are 17/min. On physical exam, she is mildly diaphoretic and restless, she has notable lid retraction, and her hair is thin. She has 4/5 strength in the proximal upper and lower extremities. Biceps and patellar tendon reflexes are 3+. Which of the following laboratory findings are most likely present in this patient?
A 70-year-old woman presents to the office for a yearly physical. She states she has recently started experiencing pain in her legs and her back. Last year, she experienced a fracture of her left arm while trying to lift groceries. The patient states that she does not consume any dairy and does not go outside often because of the pain in her legs and back. Of note, she takes carbamazepine for seizures. On exam, her vitals are within normal limits. You suspect the patient might have osteomalacia. Testing for which of the following is the next best step to confirm your suspicion?
A 22-year-old man is brought to the emergency department by ambulance 1 hour after a motor vehicle accident. He did not require any circulatory resuscitation at the scene, but he was intubated because he was unresponsive. He has no history of serious illnesses. He is on mechanical ventilation with no sedation. His blood pressure is 121/62 mm Hg, the pulse is 68/min, and the temperature is 36.5°C (97.7°F). His Glasgow coma scale (GCS) is 3. Early laboratory studies show no abnormalities. A search of the state donor registry shows that he has registered as an organ donor. Which of the following is the most appropriate next step in evaluation?
A 47-year-old woman presents to the clinic complaining of difficulty swallowing that started 1 month ago. The patient also reports a weight loss of 10 lbs during this time, without a change in her appetite. She denies fatigue, cough, hoarseness, pain, or hemoptysis. The patient has a history of childhood lymphoma, which was treated with radiation. She takes no medications. She has smoked 1 pack of cigarettes per day since she was 25 years old. Her physical exam is notable for a palpable nodule on the right side of the thyroid. An ultrasound is performed, which confirms a 1.2 cm hyperechoic nodule in the right lobe. Thyroid function labs are drawn and shown below: Serum TSH: 0.2 mU/L Serum thyroxine (T4): 187 nmol/L Serum triiodothyronine (T3): 3.3 nmol/L Which of the following is the next best step in management?
A 52-year-old woman presents to her primary care physician with symptoms of heat intolerance, unintentional weight loss, feelings of anxiety, and excessive energy that hinder her from falling asleep at night. On physical exam, the patient is found to have mildly protuberant eyes bilaterally as well as discoloration and swelling of her shins. Which of the following lab results would most likely be present in this patient?
Hypertension diagnosis and management
Practice Questions
Stable coronary artery disease
Practice Questions
Peripheral arterial disease
Practice Questions
Aortic diseases
Practice Questions
Valvular heart disease
Practice Questions
Pericardial diseases
Practice Questions
Adult congenital heart disease
Practice Questions
Cardiac tumors
Practice Questions
Cardiac manifestations of systemic diseases
Practice Questions
Pre-operative cardiac risk assessment
Practice Questions
Cardiac imaging modalities
Practice Questions
Preventive cardiology
Practice Questions
Cardiac rehabilitation
Practice Questions
Get full access to all questions, explanations, and performance tracking.
Scan to download app